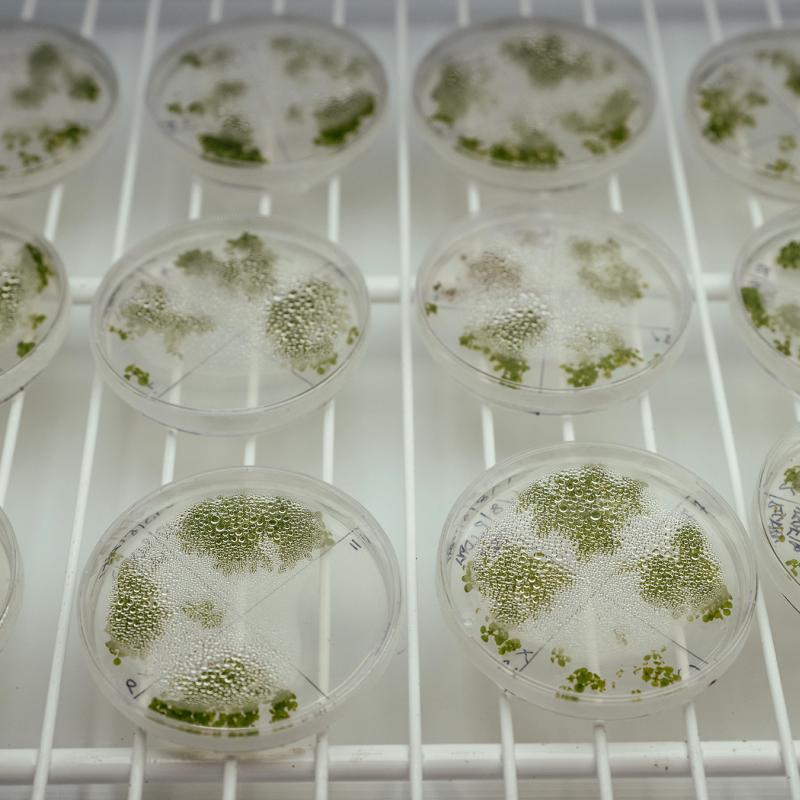
Series of petri dishes with plants in them

On top of the Biosciences Complex you’ll find big greenhouses and small growing chambers that create customized climates for growing any plant on Earth.
Prairie farmland? Sure. Tundra? Tropical paradise? Nothing simpler.
The Queen’s Phytotron lets biologists simulate any growing environment, controlling temperature, humidity, and daylight for plant research. Dr. Saeid Mobini manages all this. (“Phyto” is a Greek prefix meaning “plant.”)
Along one side are greenhouses, with six large isolated areas that can generally duplicate various environments, with temperatures between 10 C and 45 C and supplemental lighting to lengthen the day.
Dr. Jannice Friedman studies wildflowers to learn how plants adapt to change. Some of her flowers are annuals while others of the very same species are perennials. Why? How?
The conservatory houses more than 150 tropical, subtropical and Mediterranean plant species from a range of taxonomic lineages and biogeographical regions, including orchids, palms, bananas, bromeliads, cacti, birds of paradise, and more.
“We’re researching why they might have different strategies in different environments.”
The Phytotron can simulate any climate. Dr. Friedman replicates an environment on Vancouver Island, using long-term data from one Environment Canada weather station.
“And I just have to walk up two flights of stairs to get there.
“We usually begin with seed (or occasionally plants) collected from their natural environment,” she says. “We first do field work to collect the seed from the specific populations we are interested in. We then germinate that seed and grow them in the Phytotron. We will often then make specific crosses between those plants, to examine specific traits we’re interested in.
“The work we’re doing is currently tied to a lot of issues (such as) loss of pollinators and climate change.”